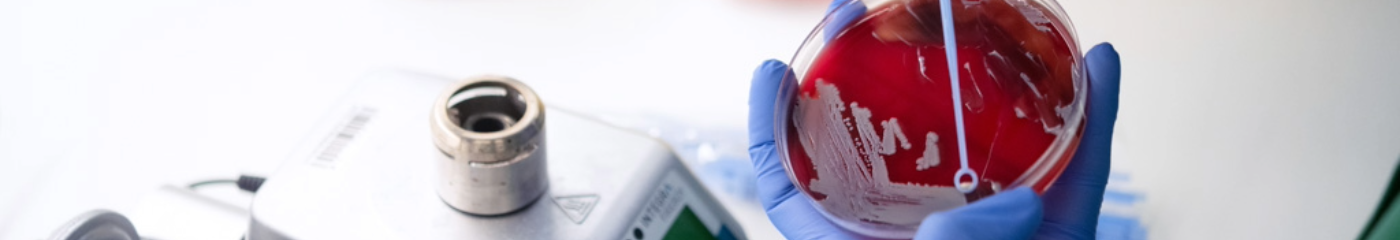
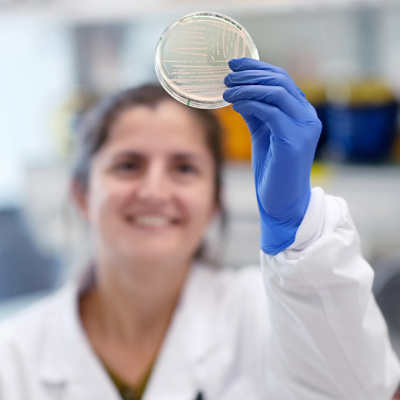

Collaboration – Openness – Equity
The AMR crisis will not be solved by science alone. To achieve our aim to transform antibiotic research, we recognise and strongly endorse collaboration, open science, and equity, within and outside our walls. We are committed to excellence and ethical conduct in all aspects of our work and we support inclusive, diverse, and equitable conduct of research.
Our multidisciplinary approach emphasises the importance of diverse perspectives, expertise, and backgrounds in tackling complex challenges related to antimicrobial resistance. Collaboration is the cornerstone of our research and of our culture, and we strive to build a working environment in which that is both possible and desirable.
Practicing open science strengthens and accelerates the impact, transparency and reproducibility of scientific research. We are committed to publishing all of our data and to giving free access to our research publications.